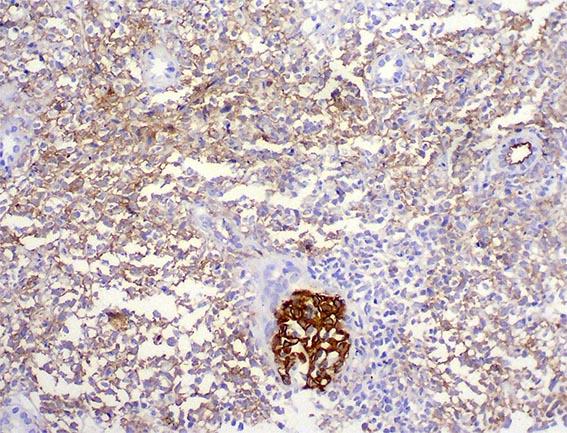
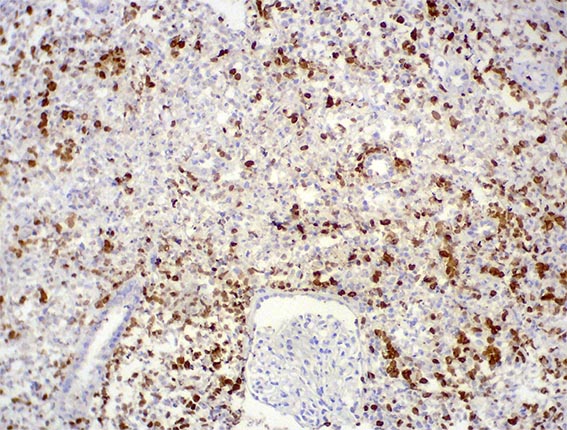
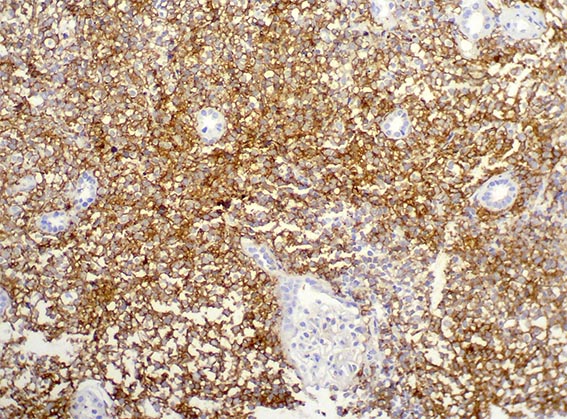

Diagnóstico
del Caso 113 Con una breve discusión |
English
version |
|||
CASO 113
Volver a datos clínicos e imágenes Caso 113
Diagnóstico: Compromiso renal por linfoma difuso de células B
La inmunohistoquímica demostró positividad difusa para CD20 y CD10, con índice proliferativo del 80% (Ki67). Caso diagnosticado por la sección de Hematopatología de nuestro Departamento.
Figura 7. Inmunohistoquímica para CD20, X400.
Figura 8. Inmunohistoquímica para CD10, X400.
Figura 9. Inmunohistoquímica para Ki67, X400.
El compromiso del parénquima renal por linfoma difuso de células B no es muy frecuente. En casi todos los casos la afectación renal es un proceso secundario, ya sea por extensión directa de una masa retroperitoneal o por diseminación hematógena en el contexto de enfermedad diseminada. El compromiso del parénquima renal no se traduce necesariamente en alteración de su función, lo que sugiere que muchos pacientes podrían tener compromiso renal subclínica al momento del diagnóstico. (Villa D, et al. Diffuse large B-cell lymphoma with involvement of the kidney: outcome and risk of central nervous system relapse. Haematologica. 2011;96(7):1002-7. [PubMed link). En nuestra paciente se documentó compromiso hepato-esplénico por el linfoma.
Bibliografía
-
Li SJ, Chen HP, Chen YH, Zhang LH, Tu YM, Liu ZH. Renal involvement in non-Hodgkin lymphoma: proven by renal biopsy. PLoS One. 2014;14;9(4):e95190. [PubMed link]
-
Villa D, Connors JM, Sehn LH, Gascoyne RD, Savage KJ. Diffuse large B-cell lymphoma with involvement of the kidney: outcome and risk of central nervous system relapse. Haematologica. 2011;96(7):1002-7. [PubMed link]
-
Takei T, Uchiyama M. Diffuse large B-cell lymphoma with involvement of the kidney. BMJ Case Rep. 2012 Jul 3;2012. [PubMed link]
-
Kowalewska J, Nicosia RF, Smith KD, Kats A, Alpers CE. Patterns of glomerular injury in kidneys infiltrated by lymphoplasmacytic neoplasms. Hum Pathol. 2011;42(6):896-903. [PubMed link]